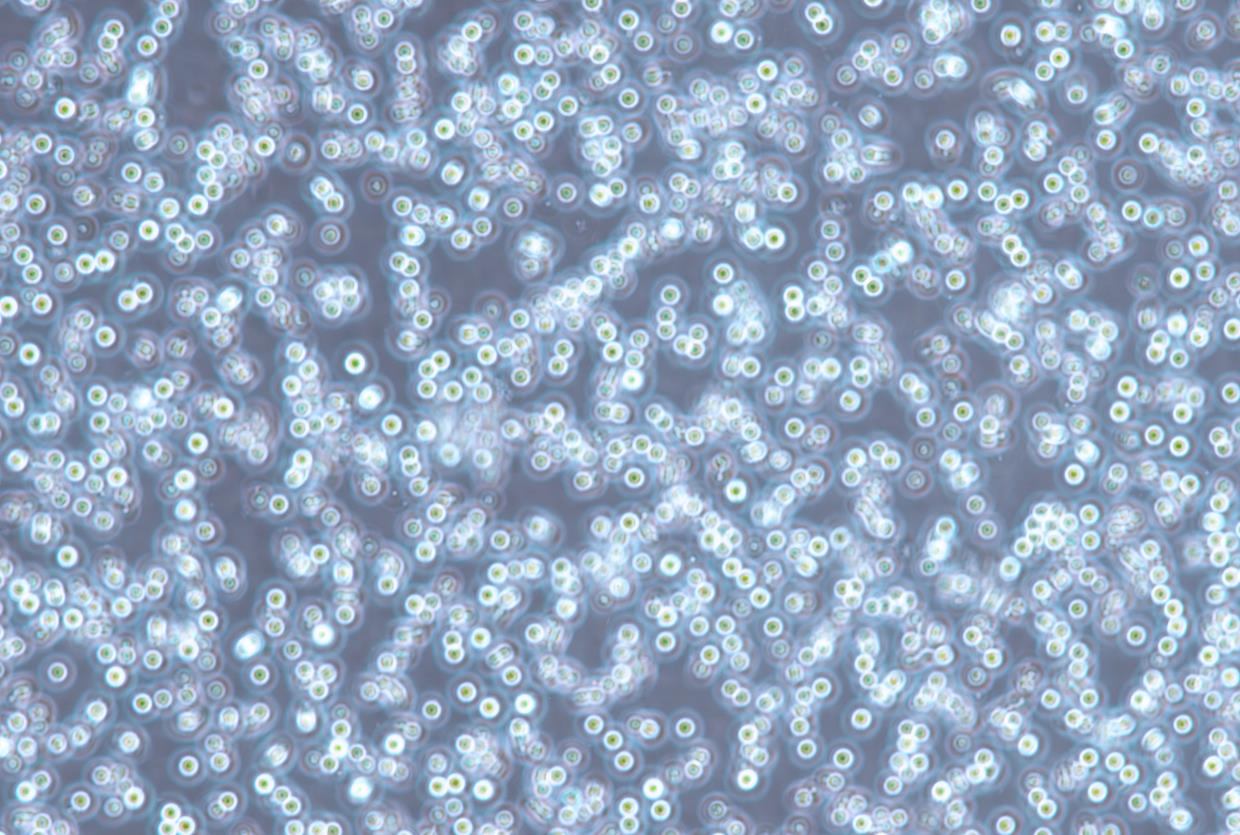

|
种属 |
人 |
|
别称 |
MM.1S;MM1-S;MM-1S;MM1S |
|
组织来源 |
外周血 |
|
疾病 |
多发性骨髓瘤 |
|
传代比例/细胞消化 |
1:2传代 |
|
完全培养基配置 |
RPMI1640培养基;10%胎牛血清;1%双抗 |
|
简介 |
该细胞系的母细胞株MM.1是从一位对类固醇疗法产生抗药性的多发性骨髓瘤患者的外周血中建立的。MM.1R对地塞 米松耐药。近缘细胞系MM.1S也是从MM.1中分离出来的,但对地塞米松敏感。 |
|
形态 |
淋巴母细胞样 |
|
生长特征 |
贴壁和悬浮混合生长 |
|
倍增时间 |
每周 2 至 3 次 |
|
基因表达 |
lambda-light chain immunoglobulin |
|
抗原表达 |
CD25+, CD38+, CD52+, CD59+ |
|
受体表达 |
glucocorticoid receptor, expressed |
|
STR |
Amelogenin X CSF1PO 9,14 D1S1656 11,12 D2S441 11 D2S1338 21,22 D3S1358 16,17 D5S818 8,12 D7S820 10,11 D8S1179 14 D10S1248 12,15 D12S391 17,24 D13S317 13 D16S539 12 D18S51 11,16 D19S433 13 D21S11 29,30 D22S1045 10,11 FGA 20,24 Penta D 2.2,9 Penta E 13,15 TH01 7,8 TPOX 8 vWA 15,17 |
|
培养条件 |
气相:空气,95%;二氧化碳,5%。温度:37摄氏度,培养箱湿度为70%-80%。 |
|
冻存条件 |
冻存液: 90%FBS, DMSO 10%, 或使用非程序冻存液: 官网货号JY-H040 |
|
保藏机构 |
ATCC; CRL-2974 |
|
备注 |
该细胞为半悬浮和半贴壁细胞,悬浮细胞离心收集,贴壁细胞消化处理 |
|
产品使用 |
仅限于科学研究, 不可作为动物或人类疾病的治疗产品使用。 |